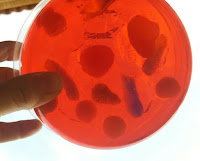

Durante estas últimas semanas los alumnos/as de 5º A y 5º B han estado investigando, observando en el microscopio y realizando modelos de células vegetales y animales. Incluso se los han comido ya que también los hicimos con gelatina y chuches de diversas formas.
Todo este trabajo está desarrollado dentro de la Unidad Didáctica "Los seres vivos".
Los trabajos están expuestos en la entrada del colegio y podéis también comprobar lo bien que están hechos en las fotos que hay en el enlace.
Fotos de toda la actividad.